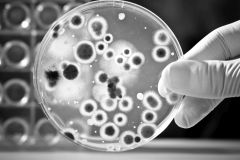

It is recommended that you complete any learning units you have started by then.
Learning Units
-

01 Arms Control basics
For several decades, arms control, non-proliferation and disarmament have played a key role in many states’ security and foreign policies. This learning unit provides a general introduction to the ...
02 Chemical Weapons
Chemical weapons (CW) are among the most gruesome means of warfare humans ever invented. This learning unit introduces CW and their effects, reviews the evolution of the norm against chemical ...
03 Biological Weapons
The Ebola crisis in West Africa (2014-16) reminded us of the challenge to contain and manage pandemic diseases in a globalised and interconnected world. Although the Ebola outbreak was a naturally ...

04 Nuclear Weapons I
Understanding nuclear proliferation requires insights into technical aspects of nuclear weapons, the size of global nuclear weapons stockpiles, former and current nuclear arms control treaties, ...

05 Nuclear Weapons II
The Nuclear Non-proliferation Treaty (NPT) is the single most important treaty covering nuclear non-proliferation and disarmament. This learning unit introduces the NPT and discusses ...

06 WMD-free Zones
While the world wrestles with the idea of a world free of nuclear weapons, some regions are already a step ahead. The whole southern hemisphere is a nuclear weapon-free zone (NWFZ) and also in the ...

07 CBRN Terrorism
Until the present day a large-scale terrorist attack carried out with weapons of mass destruction has not occurred, but it is often seen as (almost) inevitable and only a matter of time. This ...

08 Missiles And Space
In recent years space has become ever more important for both commercial and military applications. Some experts assume that the next major war will actually start in space. Given the importance of...

09 Humanitarian Arms Control I
After the Cold War, a new discourse on arms control and disarmament emerged driven, in part, by the severe humanitarian impact of landmines and explosive remnants of war on people’s lives and ...

10 Humanitarian Arms Control II
Small arms and light weapons (SALW) are responsible for the majority of violent deaths world-wide. Some critics argue that its SALW which are the real weapons of mass destruction. This learning ...

11 Arms Control In Europe
When it comes to the control of conventional weapons, Europe has an impressive track record of treaties restricting conventional weapons and fostering transparency and confidence. This learning ...

12 Export Controls
For many states, the licit export of armaments is a lucrative endeavor. In order to guarantee that only licit transfers take place, states have export control measures in place. But how do they ...

13 Compliance And Enforcement
'Trust, but verify', was a famous slogan during the Cold War in the context of arms control. However, the question of how to verify that a state is honouring its commitments is (one of) the biggest...

14 EU Disarmament And Non-Proliferation
The European Union’s engagement with matters of non-proliferation and disarmament is multi-faceted and not always easy to grasp. This learning unit will navigate through the complex institutional ...

15 Emerging Technologies
The military always aims at making use of technological progress. This can entail new weapon systems, new concepts or doctrines, or even entirely new domains of operation such as space or ...
16 Gender
While the link between gender and disarmament may not be apparent at first, gender has played an important role in disarmament affairs since the early 20th century. The learning unit will ...
17 Disarmament Law
International non-proliferation and disarmament law forms part of international law and constitutes one of international law’s many sub-regimes. It addresses very specific issues of major ...
18 UN Disarmament Machinery
Humankind has always been perturbed by the use of particularly cruel means of war. As a result, a number of actions have been taken to restrict such use. The establishment of the United Nations ...
19 Cyberconflict and Cyberstrategy
Hardly a day passes without bad news from the cyber sector: Cyberattacks against state and military institutions are now almost the norm, and private individuals must be enormously wary of phishing...
20 Arms Control History
This learning unit aims to provide a brief history of arms control in a classical chronological order, focusing primarily on the West, from antiquity to the present. In doing so, it postulates that...
Certificates
Test your knowledge and receive the Basic Certificate for completing the first five, and the Comprehensive Certificate for completing all 20 learning units.
All learning unit content is accessible without registration, but a free account is required to access the certificate section. If you don't have an account, you can register here. Terms apply.
First time here? Create a new account.
Contributors




